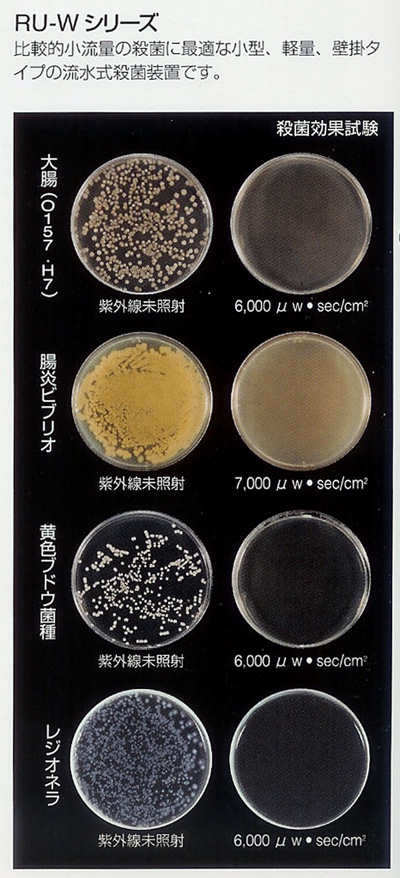

|

※こちらの商品は受注生産商品になりますので
お届けまでに一ヶ月~一ヵ月半お時間を頂く場合があります。
RU-S1 
RU-S2 
RU-S3 
RU-S4 
RU-S6 
RU-S8 
RU-S12 
RU-S16 
RU-S25 
RU-Sランプ(コネクタータイプ)

RU-Sランプ(Y端子ランプ)

RU-H1 
RU-H2 
RU-H3 
RU-H4 
RU-H6 
RU-H8 
RU-H12 
RU-H16 
RU-H25 
RU-Hランプ(コネクターランプ)

RU-Hランプ(Y端子ランプ)

RU-W1 
RU-W2 
RU-W4 
RU-W5 
RU-W7 
RU-W10 
RU-W20
RU-W30
RU-W1交換ランプ 
RU-W2 交換ランプ 
RU-W4 交換ランプ 
RU-W5 交換ランプ 
RU-W7 交換ランプ 
RU-W10 交換ランプ  |